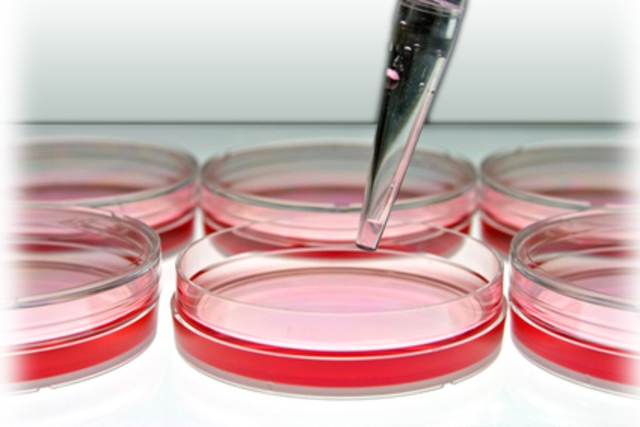
ensayos preliminares

-
En esta se dice que las celulas son autosuficiente y presentan la posibilidad de regenerar plantas completas.
-
Plantean que los principales nutrientes de plantas eran inorgánicos y la consiguiente preparación de soluciones nutritivas se considera un gran aporte a las técnicas de cultivo in vitro.
-
incidieron en el establecimiento y desarrollo de los sistemas in vitro comienzan con los aportes de sacks y knops
-
inicio cultivos de celulas a partir del mesófilo de celulas muy diferenciadas en tradescantia, ornithogalum y erithromium. en la universidad de graz (australia).
-
hanning logro el aislamiento de enbriones inmaduros de crucíferas; mostrando lo importante del cultivo de embriones y su aplicacion con cruzamientos de linum perenne x L. austriacum, recuperando plantas normales.
-
harrison, burrows y carrel tuvieron exito al cultivar in vitro tejido animal y humano.
-
en la universidad de missouri en norteamerica haberlandt y kotte lograron desarrollar raices de tomate y mantenerlas en cultivo durante varios meses. se conocen como pioneros en la obtencion de desarrollo de raices.
-
knudson establecio el medio de cultivo para la germinacion asimbiotica de semillas de orquidea. el primer exito de hibridos interespecificos fue obtenido por laibach con el cultivo de embriones producidos por cruces de linum perene y linium austriacum.
-
white en estados unidos, paralelamente con nobecurt y gautheret en francia, lograron el crecimiento indefinido de tejido de raiz; al mismo tiempo, observaron las callosidades en raices de zanahoria y tabaco que, al ser aisladas a un medio de cultivo semisólido, evidenciaron el desarrollo progresivo de celulas sin diferenciar, las denominaron callo (callus).
-
emplearon por primera vez el agua de coco para el cultivo de embriones en datura. folke skoog, en 1944, obtiene los primeros cultivos de tabaco in vitro para estudiar la formacion de vastagos adventicios.
-
se logro cultivar por primera vez tejido de agalla de corona, libre de la bacteria inductora en el medio definido que contenia sacarosa y sales inorganicas en ausencia de hormonas endógenas.
-
la zamia fiolidiana fue cultivada demostrando que el polen puede desarrollarse en un medio de cultivo adecuado.
-
ball obtuvo por primera vez la regeneracion de organos a partir de callos seuoia sempervirels.
-
G.morel y C. Martin demostraron que, en determindas partes de la planta, los tejidos meristematicos tenian la capacidad de desarrollar plantas completas en condiciones in vitro.
-
burming en alemania en la universidad de harvard, considero que el inicio del desarrollo organizado de cada celula vegetal viviente capaz de regenerar estimulos puede dividirse en meristemoide potencialmente capaz y geneticamente apto parea dividirse.
-
Watson, crack y wilkins establecieron la estructura molecular de la doble elice del acido desoxiribonucleico.
-
esta sustancia constituyo un nuevo impulso para el desarrollo de los sistemas in vitro como regulador de crecimiento que para los investigadores se convirtio en una herramienta esencial en trabajos esperimentales relacionados con los de morfogenesis y crecimiento.
-
skoog y miller reportaron el control de la formacion de brotes y raices en tabaco utilizando diferentes concentraciones de auxinas y citoquininas.
-
obtuvieron la regeneracion in vitro de embriones somaticos a partir de nucela y ovulos de citrus spp.
-
cocking utilizo la enzima celulasa para realizar la degradacion de la pared celular, logrando el aislamiento de protoplastos.
Want to make a timeline like this?
Use Timetoast to turn dates, events, milestones, and phases into a clear visual timeline you can build and share. Timetoast is a timeline maker for work, school, research, and stories.